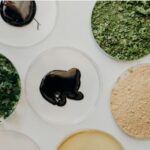
Algae-Based UV Flexo Ink Sets a New Standard for Sustainable Label Printing! Algae-Based UV Ink Flexo Ink Sustainable Label Printing Packaging Innovation Eco-Friendly Food and Beverage Business

Perlen Industrieholding AG is advancing its journey towards becoming a multifaceted industrial leader by partnering as the exclusive manufacturing ally for Pulpex, the UK’s frontrunner in eco-friendly packaging solutions.
This collaboration grants Perlen the unique rights to produce Pulpex’s innovative paper bottles in Switzerland, Austria, Italy, and the southern regions of Germany. The company is presently evaluating how to implement this technology on an industrial scale, with an ultimate decision on production expected by 2027.
The Pulpex innovation marks a substantial advancement in combating plastic pollution. These fiber-based bottles not only offer outstanding strength and water resistance but also significantly reduce the carbon footprint, achieving reductions of up to 90% compared to conventional glass containers.
Highlights of this new packaging solution include:
– Complete recyclability: Recognized as recyclable within standard paper waste systems (tested by 4evergreen).
– Food-grade protection: An odor-neutral barrier coating ensures an appealing shelf life for consumers.
– Versatile applications: Suitable for a wide range of products, including water, juices, milk, beauty items, wines, and spirits.
This partnership capitalizes on the already established infrastructure of Perlen Papier AG. With its considerable expertise in fiber, the site has the potential to establish a truly closed-loop system: the bottles can be disposed of in typical household paper recycling, returned to the Perlen facility, and converted back into raw materials for new packaging solutions.
“By securing exclusive rights with Pulpex, we can introduce a leading-edge solution for sustainable packaging to our primary markets,” stated Dr. Florian Geiger, CEO of Perlen Industrieholding AG. “The paper bottle addresses essential consumer demands for resource-efficient packaging while enabling us to utilize our expertise to enhance value through a functional circular economy.”
For Pulpex, this agreement signifies the initial phase of an ambitious global expansion strategy. The company’s goal is to enable its manufacturing partners to replace over a billion plastic and glass bottles by the year 2030.
Sandy Westwater, CEO of Pulpex, remarked: “The integration of Pulpex’s pioneering, scalable technology with Perlen’s industrial proficiency exemplifies how a viable alternative to existing packaging formats can be swiftly introduced to the market. This collaboration is a significant first step towards providing brand owners and consumers with a genuinely sustainable option.”